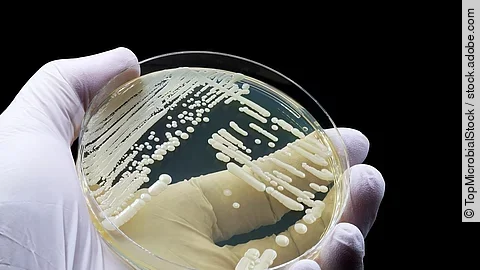
Eine Petrischale wird einer Hand mit Handschuhen gehalten.

Motorisches Lernen, beispielsweise das Spielen eines Instruments, präzise Bewegungen beim Sport oder auch die korrekte Betonung einer neuen Sprache, fällt in jungen Jahren besonders leicht. Was aber, wenn sich diese jugendliche Lernfähigkeit auch im Alter reaktivieren ließe? Die Forschungsgruppe von Daniela Vallentin am Max-Planck-Institut für biologische Intelligenz konnte an Zebrafinken zeigen, dass dies tatsächlich möglich ist. Die Forschungsergebnisse deuten darauf hin, dass eine Reaktivierung bestimmter für das Gesangslernen im Jungvogel wichtiger Mechanismen in ausgewachsenen Zebrafinken möglich ist und die Lernfähigkeit der Tiere positiv beeinflusst.
Im Alter lernt man schlechter – aber warum?
Je älter wir werden, desto schwerer fällt es uns, neue Fähigkeiten zu erlernen. Besonders deutlich wird dies beim Erlernen einer Fremdsprache: Unbekannte Laute und komplizierte Grammatik wollen einfach nicht im Gedächtnis bleiben.
Schuld daran ist vor allem die mit zunehmendem Alter nachlassende Plastizität unseres Gehirns. Die Fähigkeit, sich durch eine Neuverknüpfung von Nervenzellen und der Anpassung ganze Hirnareale neuen Herausforderungen zu stellen, nimmt im Alter rapide ab. Doch neueste Forschungsergebnisse geben Hoffnung: Es scheint, als könne die jugendliche Lernfähigkeit auch im Alter reaktiviert werden.
Neben der allgemeinen Abnahme neuronaler Plastizität im Alter kann die Aktivität bestimmter motorische Lernzentren im Gehirn auch an spezifische Entwicklungsphasen gebunden sein. Ein Beispiel für solche an ein konkretes Alter gebundene neuronalen Prozesse findet man beim männlichen Zebrafinken. Die Tiere erlernen ihren Gesang ausschließlich in den ersten 90 Tagen ihres Lebens. Nach dieser jugendlichen Lernphase nimmt die Plastizität im Gehirn der Vögel stark ab und spezialisierte Nervenzellen unterdrücken die Fähigkeit, Gelerntes weiter zu verändern.
Dies wirft eine spannende Frage auf: Würden auch ältere Vögel wieder Neues lernen, wenn man die hemmende Aktivität diese Neuronen unterdrücken und somit die Plastizität des Gehirns wiederherstellen könnte?
Lernfähigkeit konnte wiederhergestellt werden
In einer neuen Studie unter der Leitung von Daniela Vallentin haben Forschende genau diese Frage untersucht. Mit Hilfe modernster Methoden wie der zellspezifischen Optogenetik gelang es dem internationalen Team, die hemmenden Nervenzellen gezielt auszuschalten. Das Ergebnis war erstaunlich: Die Lernfähigkeit erwachsener Zebrafinken wurde tatsächlich wiederhergestellt. Die Tiere waren in der Lage, ihrem bestehenden Gesang neue Elemente hinzuzufügen, ohne die bereits gelernten Elemente zu beeinträchtigen. "Wir konnten eine bisher unbeobachtete Erweiterung des Gesangsrepertoires der adulten Tiere feststellen", berichtet Fabian Heim, Erstautor der Studie.
Das Gesangslernen beim Zebrafinken ist nur eines vieler Beispiele für solche spezifischen Lernphasen, selbst das Erlernen bestimmter sozialer Verhaltensweisen bei Mäusen ist an entsprechende Zeiträume gebunden. Die Ergebnisse dieser Studie tragen somit neben dem besseren Verständnis des Gesangslernprozesses auch dazu bei, die Regulation solcher zeitlich beschränkten Lernphasen generell zu entschlüsseln.
Originalpublikation
Die Originalveröffentlichung "Disinhibition enables vocal repertoire expansion after a critical period" erschien in der Nature Communications.
Quellen (nach Angaben von):
Was Hänschen nicht lernt, lernt Hans eben später - Reaktivierung der Lernfähigkeit von Zebrafinken im Alter (bi.mpg.de) 02.09.2024
Was Hänschen nicht lernt, lernt Hans eben später - Reaktivierung der Lernfähigkeit von Zebrafinken im Alter (idw-online.de) 02.09.2024
(IR)